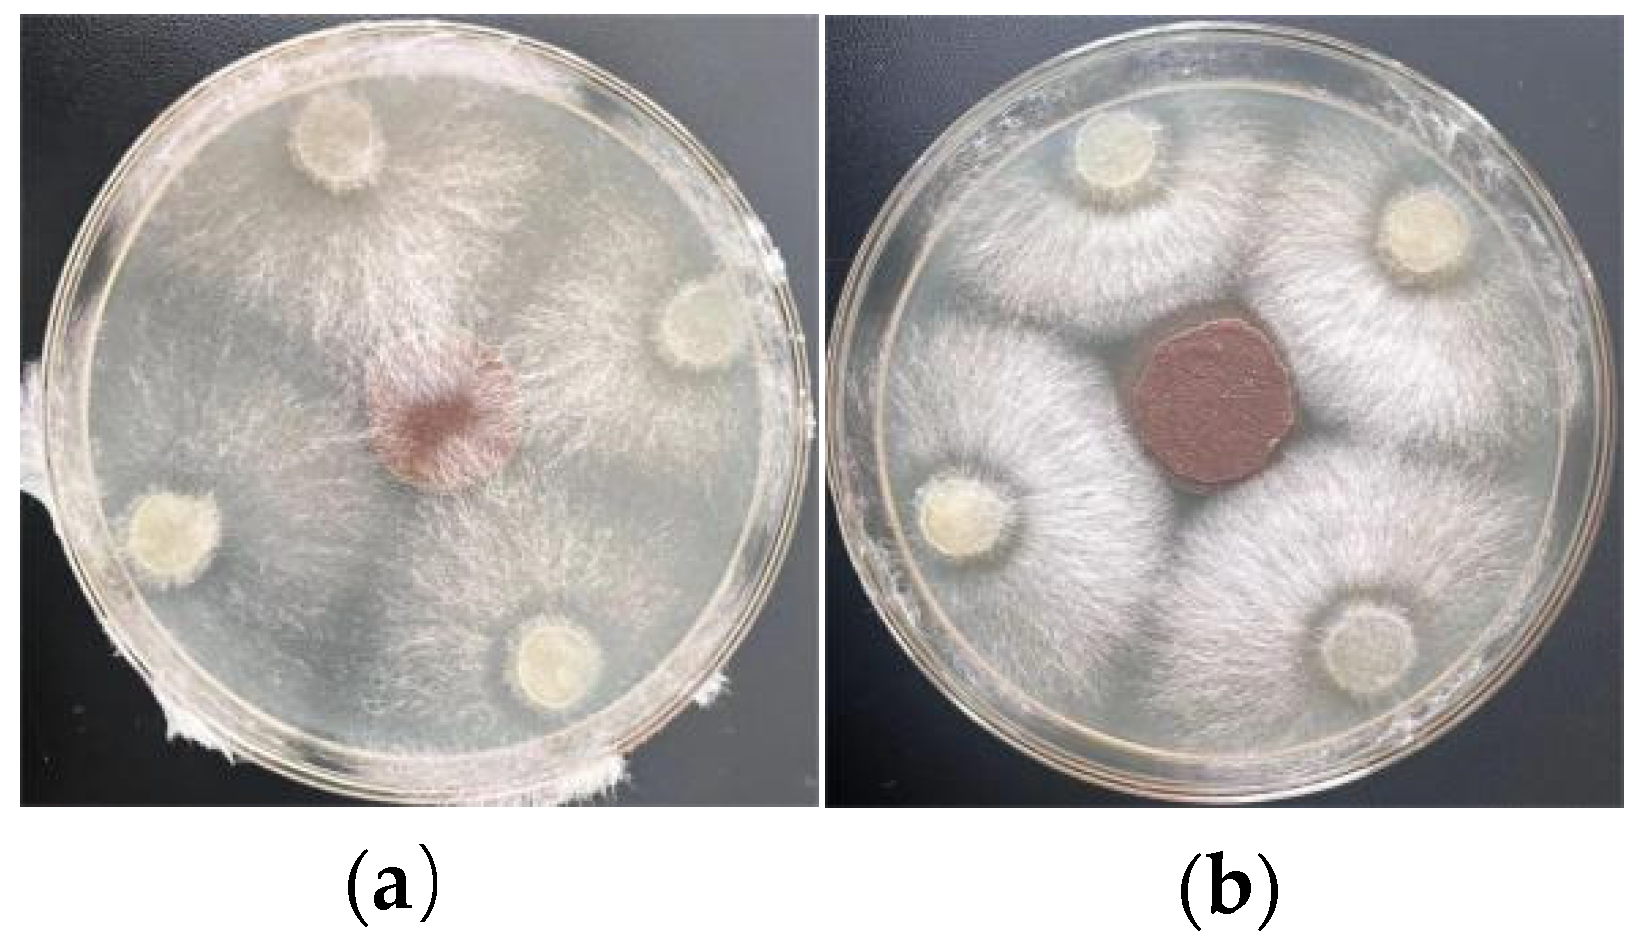
Agronomy 15 00071 g010

Preparation of Wheat-Straw-Fiber-Based Degradable Mulch Film for Sustained Release of Carbendazim and Its Application for Soybean Root Rot Control
Abstract
1. Introduction
2. Materials and Methods
2.1. Materials
2.2. Preparation of WFM
2.3. Preparation of C-CS-WFM
2.4. Experimental Design and Statistical Analysis
2.5. Performance Measurement and Characterization
2.5.1. Measurement of Mechanical Properties
2.5.2. Measurement of Air Permeance
2.5.3. SEM
2.5.4. FT-IR
2.6. Drug Release Kinetics
2.7. In Vitro Antifungal Properties
2.8. Pot Experiment
3. Results
3.1. Optimization of C-CS-WFM Performance
3.1.1. Experimental Results and Regression Model
3.1.2. Influence of Test Factors on DTS
3.1.3. Influence of Test Factors on WTS
3.1.4. Influence of Test Factors on AP
3.1.5. Optimization and Model Verification
3.2. FT-IR Spectroscopy
3.3. Drug Release Kinetics
3.4. Antifungal Properties and Pot Experiment
4. Discussion
4.1. Physical Properties of C-CS-WFM
4.2. Drug Release Performance of C-CS-WFM
4.3. Cost and Environmental Impact
5. Conclusions
Author Contributions
Funding
Data Availability Statement
Conflicts of Interest
References
- Williamson-Benavides, B.A.; Dhingra, A. Understanding Root Rot Disease in Agricultural Crops. Horticulturae 2021, 7, 33. [Google Scholar] [CrossRef]
- Liu, Y.; Wei, X.; Chang, F.; Yu, N.; Guo, C.; Cai, H. Distribution and Pathogenicity of Fusarium Species Associated with Soybean Root Rot in Northeast China. Plant Pathol. J. 2023, 39, 575–583. [Google Scholar] [CrossRef] [PubMed]
- Martins, P.M.M.; Merfa, M.V.; Takita, M.A.; De Souza, A.A. Persistence in Phytopathogenic Bacteria: Do We Know Enough? Front. Microbiol. 2018, 9, 1099. [Google Scholar] [CrossRef] [PubMed]
- Xi, X.; Fan, J.; Yang, X.; Liang, Y.; Zhao, X.; Wu, Y. Evaluation of the Anti-Oomycete Bioactivity of Rhizosphere Soil-Borne Isolates and the Biocontrol of Soybean Root Rot Caused by Phytophthora Sojae. Biol. Control 2022, 166, 104818. [Google Scholar] [CrossRef]
- Rodriguez, M.C.; Sautua, F.; Scandiani, M.; Carmona, M.; Asurmendi, S. Current Recommendations and Novel Strategies for Sustainable Management of Soybean Sudden Death Syndrome. Pest Manag. Sci. 2021, 77, 4238–4248. [Google Scholar] [CrossRef]
- Yang, Q.; Yang, X.; Huang, X.; Ye, W.; Wang, T.; Cheng, Z.; Shi, J.; Li, Y.; Xu, J.; He, Y. Seed Coating with Fungicide Causes a Beneficial Shift in Root-associated Microbiomes of Mature Soybean. Soil Sci. Soc. Am. J. 2023, 87, 43–62. [Google Scholar] [CrossRef]
- Li, G.-B.; Wang, J.; Kong, X.-P. Coprecipitation-Based Synchronous Pesticide Encapsulation with Chitosan for Controlled Spinosad Release. Carbohydr. Polym. 2020, 249, 116865. [Google Scholar] [CrossRef] [PubMed]
- Luo, J.; Gao, Y.; Liu, Y.; Huang, X.; Zhang, D.; Cao, H.; Jing, T.; Liu, F.; Li, B. Self-Assembled Degradable Nanogels Provide Foliar Affinity and Pinning for Pesticide Delivery by Flexibility and Adhesiveness Adjustment. ACS Nano 2021, 15, 14598–14609. [Google Scholar] [CrossRef] [PubMed]
- Yang, F.; He, B.; Dong, B.; Zhang, G. Film-Straw Dual Mulching Improves Soil Fertility and Maize Yield in Dryland Farming by Increasing Straw-Degrading Bacterial Abundance and Their Positive Cooperation. Agric. Ecosyst. Environ. 2024, 367, 108997. [Google Scholar] [CrossRef]
- Saberi Riseh, R. Advancing Agriculture through Bioresource Technology: The Role of Cellulose-Based Biodegradable Mulches. Int. J. Biol. Macromol. 2024, 255, 128006. [Google Scholar] [CrossRef] [PubMed]
- Mansoor, Z.; Tchuenbou-Magaia, F.; Kowalczuk, M.; Adamus, G.; Manning, G.; Parati, M.; Radecka, I.; Khan, H. Polymers Use as Mulch Films in Agriculture—A Review of History, Problems and Current Trends. Polymers 2022, 14, 5062. [Google Scholar] [CrossRef]
- Wen, S.; Dang, P.; Li, D.; Qin, X.; Siddique, K.H.M. Effects of Semi-Film and Full-Film Mulching on Soybean Growth, Biological Nitrogen Fixation and Grain Yield. J. Agron. Crop Sci. 2024, 210, e12724. [Google Scholar] [CrossRef]
- Merino, D.; Simonutti, R.; Perotto, G.; Athanassiou, A. Direct Transformation of Industrial Vegetable Waste into Bioplastic Composites Intended for Agricultural Mulch Films. Green Chem. 2021, 23, 5956–5971. [Google Scholar] [CrossRef]
- Wang, Q.; Duan, Y.; Huang, Y.; Teng, Y.; Li, C.; Tao, Y.; Lu, J.; Du, J.; Wang, H. Multifunctional Soybean Protein Isolate-Graft-Carboxymethyl Cellulose Composite as All-Biodegradable and Mechanically Robust Mulch Film for “Green” Agriculture. Carbohydr. Polym. 2024, 323, 121410. [Google Scholar] [CrossRef] [PubMed]
- Sukwijit, C.; Seubsai, A.; Charoenchaitrakool, M.; Sudsakorn, K.; Niamnuy, C.; Roddecha, S.; Prapainainar, P. Production of PLA/Cellulose Derived from Pineapple Leaves as Bio-Degradable Mulch Film. Int. J. Biol. Macromol. 2024, 270, 132299. [Google Scholar] [CrossRef] [PubMed]
- Parida, M.; Jena, T.; Mohanty, S.; Nayak, S.K. Advancing Sustainable Agriculture: Evaluation of Poly (Lactic Acid) (PLA) Based Mulch Films and Identification of Biodegrading Microorganisms among Soil Microbiota. Int. J. Biol. Macromol. 2024, 269, 132085. [Google Scholar] [CrossRef] [PubMed]
- Kochkina, N.E.; Lukin, N.D. Structure and Properties of Biodegradable Maize Starch/Chitosan Composite Films as Affected by PVA Additions. Int. J. Biol. Macromol. 2020, 157, 377–384. [Google Scholar] [CrossRef] [PubMed]
- Uyarcan, M.; Güngör, S.C. Improving Functional Properties of Starch-Based Films by Ultraviolet (UV-C) Technology: Characterization and Application on Minced Meat Packaging. Int. J. Biol. Macromol. 2024, 282, 137085. [Google Scholar] [CrossRef]
- Xie, Z.; Xiong, Q.; Fang, Y.; Zhang, Q.; Liang, W.; Cheng, J.; Shang, W.; Zhao, W.; Zhao, J. Novel Biodegradable Composite Mulch Film Embedded with Temperature-Responsive Pesticide Microcapsules for Durable Control of Phytophthora Root Rot on Soybean. ACS Sustain. Chem. Eng. 2023, 11, 9868–9879. [Google Scholar] [CrossRef]
- Othman, N.A.F.; Selambakkannu, S.; Seko, N. Biodegradable Dual-Layer Polyhydroxyalkanoate (Pha)/Polycaprolactone (Pcl) Mulch Film for Agriculture: Preparation and Characterization. Energy Nexus 2022, 8, 100137. [Google Scholar] [CrossRef]
- Lv, Z.; Meng, X.; Liang, Q.; Jiang, T.; Sun, S.; Tan, Y.; Feng, J. A Biodegradable Oxidized Starch/Carboxymethyl Chitosan Film Coated with Pesticide-Loaded ZIF-8 for Tomato Fusarium Wilt Control. Int. J. Biol. Macromol. 2024, 259, 129249. [Google Scholar] [CrossRef] [PubMed]
- Rehman, A.; Feng, J.; Qunyi, T.; Korma, S.A.; Assadpour, E.; Usman, M.; Han, W.; Jafari, S.M. Pesticide-Loaded Colloidal Nanodelivery Systems; Preparation, Characterization, and Applications. Adv. Colloid Interface Sci. 2021, 298, 102552. [Google Scholar] [CrossRef]
- Saberi Riseh, R.; Vatankhah, M.; Hassanisaadi, M.; Kennedy, J.F. Macromolecules-Based Encapsulation of Pesticides with Carriers: A Promising Approach for Safe and Effective Delivery. Int. J. Biol. Macromol. 2024, 269, 132079. [Google Scholar] [CrossRef] [PubMed]
- Zhou, L.; Wang, H.; Sun, F. Environmentally Responsive Mulch Films for Sustainable Pest Control. Adv. Agric. Technol. 2022, 7, 145–160. [Google Scholar]
- Lv, Z.; Meng, X.; Sun, S.; Jiang, T.; Zhang, S.; Feng, J. Biodegradable Carboxymethyl Chitosan/Polyvinyl Alcohol Hymexazol-Loaded Mulch Film for Soybean Root Rot Control. Agronomy 2023, 13, 2205. [Google Scholar] [CrossRef]
- Chen, G.; Cao, L.; Cao, C.; Zhao, P.; Li, F.; Xu, B.; Huang, Q. Effective and Sustained Control of Soil-Borne Plant Diseases by Biodegradable Polyhydroxybutyrate Mulch Films Embedded with Fungicide of Prothioconazole. Molecules 2021, 26, 762. [Google Scholar] [CrossRef] [PubMed]
- Liang, W.; Zhao, Y.; Xiao, D.; Cheng, J.; Zhao, J. A Biodegradable Water-Triggered Chitosan/Hydroxypropyl Methylcellulose Pesticide Mulch Film for Sustained Control of Phytophthora Sojae in Soybean (Glycine max L. Merr.). J. Clean. Prod. 2020, 245, 118943. [Google Scholar] [CrossRef]
- Zhao, C.S.; Zuo, P.; Wang, X.; He, Y.-Z.; Chen, H.-T.; Zhang, Y.; Li, L.-H. Parameter Optimization of a Biodegradable Agricultural Film Manufactured with Wheat Straw Fiber. BioResources 2022, 17, 2331–2346. [Google Scholar] [CrossRef]
- Gumber, S.; Kanwar, S.; Mazumder, K. Properties and Antimicrobial Activity of Wheat-Straw Nanocellulose-Arabinoxylan Acetate Composite Films Incorporated with Silver Nanoparticles. Int. J. Biol. Macromol. 2023, 246, 125480. [Google Scholar] [CrossRef] [PubMed]
- Li, R.; Wang, Z.; Dong, H.; Yang, M.; Sun, X.; Zong, Q.; Xu, Z. Lattice Boltzmann Modeling of the Effective Thermal Conductivity in Plant Fiber Porous Media Generated by Quartet Structure Generation Set. Mater. Des. 2023, 234, 112303. [Google Scholar] [CrossRef]
- Li, Y.; Liu, C.; Gai, X.; Deng, C.; Wei, H.; Liu, Y.; Xiao, H. Mulch from Lignocellulose as Agricultural Plastic Alternative for Sustained-Release of Photosensitive Pesticide. Int. J. Biol. Macromol. 2024, 255, 128347. [Google Scholar] [CrossRef]
- Francolini, I.; Galantini, L.; Rea, F.; Di Cosimo, C.; Di Cosimo, P. Polymeric Wet-Strength Agents in the Paper Industry: An Overview of Mechanisms and Current Challenges. Int. J. Mol. Sci. 2023, 24, 9268. [Google Scholar] [CrossRef] [PubMed]
- Wang, S.; Jing, Y. Effects of a Chitosan Coating Layer on the Surface Properties and Barrier Properties of Kraft Paper. BioResources 2016, 11, 1868–1881. [Google Scholar] [CrossRef]
- Zhou, Y.; Wu, J.; Zhou, J.; Lin, S.; Cheng, D. pH-Responsive Release and Washout Resistance of Chitosan-Based Nano-Pesticides for Sustainable Control of Plumeria Rust. Int. J. Biol. Macromol. 2022, 222, 188–197. [Google Scholar] [CrossRef]
- Bakshi, P.S.; Selvakumar, D.; Kadirvelu, K.; Kumar, N.S. Chitosan as an Environment Friendly Biomaterial—A Review on Recent Modifications and Applications. Int. J. Biol. Macromol. 2020, 150, 1072–1083. [Google Scholar] [CrossRef]
- GB/T 24325-2009; Pulps--Laboratory Beating-Valley Beater Method. Standardization Administration of China: Beijing, China, 2009.
- GB/T 12914-2018; Paper and Board-Determination of Tensile Properties Constant Rate of Elongation Method (20 Mm/Min). Standardization Administration of China: Beijing, China, 2018.
- GB/T 465.2-2008; Paper and Board-Determination of Tensilestrength After Immersion in Water. Standardization Administration of China: Beijing, China, 2008.
- GB/T 458-2008; Paper and Board-Determination of Air Permeance. Standardization Administration of China: Beijing, China, 2008.
- GB/T 5009.188-2003; Determination of Thiophanate-Methyl, Carbendazimin Vegetables and Fruits. Standardization Administration of China: Beijing, China, 2003.
- GB/T 17980.88-2004; Pesticide—Guidelines for the Field Efficacy Trials (II)—Part 88: Fungicides Against Root Rot of Soybean. Standardization Administration of China: Beijing, China, 2004.
- Tanpichai, S.; Witayakran, S.; Wootthikanokkhan, J.; Srimarut, Y.; Woraprayote, W.; Malila, Y. Mechanical and Antibacterial Properties of the Chitosan Coated Cellulose Paper for Packaging Applications: Effects of Molecular Weight Types and Concentrations of Chitosan. Int. J. Biol. Macromol. 2020, 155, 1510–1519. [Google Scholar] [CrossRef]
- Tanpichai, S.; Srimarut, Y.; Woraprayote, W.; Malila, Y. Chitosan Coating for the Preparation of Multilayer Coated Paper for Food-Contact Packaging: Wettability, Mechanical Properties, and Overall Migration. Int. J. Biol. Macromol. 2022, 213, 534–545. [Google Scholar] [CrossRef] [PubMed]
- Zang, Y.H.; Aspler, J.S. The Effect of Surface Binder Content on Print Density and Ink Receptivity of Coated Paper. J. PULP Pap. Sci. 1998, 24, 141–145. [Google Scholar]
- Wang, S.; Jing, Y. Effects of Formation and Penetration Properties of Biodegradable Montmorillonite/Chitosan Nanocomposite Film on the Barrier of Package Paper. Appl. Clay Sci. 2017, 138, 74–80. [Google Scholar] [CrossRef]
- Reis, A.B.; Yoshida, C.M.P.; Reis, A.P.C.; Franco, T.T. Application of Chitosan Emulsion As A Coating on Kraft Paper. Polym. Int. 2011, 60, 963–969. [Google Scholar] [CrossRef]
- Quyen, D.T.M.; Adisak, J.; Rachtanapun, P. Relationship between Solubility, Moisture Sorption Isotherms and Morphology of Chitosan/Methylcellulose Films with Different Carbendazim Content. J. Agric. Sci. 2012, 4, p187. [Google Scholar] [CrossRef]
- Sandhya; Kumar, S.; Kumar, D.; Dilbaghi, N. Preparation, Characterization, and Bio-Efficacy Evaluation of Controlled Release Carbendazim-Loaded Polymeric Nanoparticles. Environ. Sci. Pollut. Res. Int. 2016, 24, 926–937. [Google Scholar] [CrossRef]
- Negi, G.; Pankaj; Srivastava, A.; Sharma, A. In Situ Biodegradation of Endosulfan, Imidacloprid, and Carbendazim Using Indigenous Bacterial Cultures of Agriculture Fields of Uttarakhand, India. World Acad. Sci. Eng. Technol. Int. J. Biotechnol. Bioeng. 2014, 1, 973–981. [Google Scholar]
- Wang, R.; Liu, Y.; Lu, Y.; Liang, S.; Zhang, Y.; Zhang, J.; Shi, R.; Yin, W. Fabrication of a Corn Stalk Derived Cellulose-Based Bio-Adsorbent to Remove Congo Red from Wastewater: Investigation on Its Ultra-High Adsorption Performance and Mechanism. Int. J. Biol. Macromol. 2023, 241, 124545. [Google Scholar] [CrossRef] [PubMed]
- Siepmann, J.; Peppas, N.A. Modeling of Drug Release from Delivery Systems Based on Hydroxypropyl Methylcellulose (HPMC). Adv. Drug Deliv. Rev. 2001, 48, 139–157. [Google Scholar] [CrossRef]
- Haapala, T.; Palonen, P.; Korpela, A.; Ahokas, J. Feasibility of Paper Mulches in Crop Production —A Review. Agric. Food Sci. 2014, 23, 60–79. [Google Scholar] [CrossRef]
- Li, A.; Zhang, J.; Ren, S.; Zhang, Y.; Zhang, F. Research Progress on Preparation and Field Application of Paper Mulch. Environ. Technol. Innov. 2021, 24, 101949. [Google Scholar] [CrossRef]
- Saglam, M.; Sintim, H.Y.; Bary, A.I.; Miles, C.A.; Ghimire, S.; Inglis, D.A.; Flury, M. Modeling the Effect of Biodegradable Paper and Plastic Mulch on Soil Moisture Dynamics. Agric. Water Manag. 2017, 193, 240–250. [Google Scholar] [CrossRef]
- Marí, A.I.; Pardo, G.; Cirujeda, A.; Martínez, Y. Economic Evaluation of Biodegradable Plastic Films and Paper Mulches Used in Open-Air Grown Pepper (Capsicum annum L.) Crop. Agronomy 2019, 9, 36. [Google Scholar] [CrossRef]
- McKnight, C.; Qiu, F.; Luckert, M.; Hauer, G. Prices for a Second-generation Biofuel Industry in Canada: Market Linkages between Canadian Wheat and US Energy and Agricultural Commodities. Can. J. Agric. Econ. Can. Agroecon. 2021, 69, 337–351. [Google Scholar] [CrossRef]
- Teixeira, L.V.; Bomtempo, J.V.; Oroski, F.D.A.; Coutinho, P.L.D.A. The Diffusion of Bioplastics: What Can We Learn from Poly(Lactic Acid)? Sustainability 2023, 15, 4699. [Google Scholar] [CrossRef]
- Wang, B.X.; CortesPeña, Y.; Grady, B.P.; Huber, G.W.; Zavala, V.M. Techno-Economic Analysis and Life Cycle Assessment of the Production of Biodegradable Polyaliphatic–Polyaromatic Polyesters. ACS Sustain. Chem. Eng. 2024, 12, 9156–9167. [Google Scholar] [CrossRef]

| Factors | Levels Used, Actual (Coded Factor) | ||
|---|---|---|---|
| Independent Variables | Low (−1) | Medium (0) | High (+1) |
| X1 = Chitosan concentration (%) | 1.5 | 2.0 | 2.5 |
| X2 = Wet film thickness (μm) | 15 | 20 | 25 |
| X3= Carbendazim loading (g/m2) | 0.05 | 0.10 | 0.15 |
| Run | Independent Variables | Dependent Variables | ||||
|---|---|---|---|---|---|---|
| Chitosan Concentration (%) | Wet Film Thickness (μm) | Carbendazim Loading (g/m2) | Dry Tensile Strength (kN/m) | Wet Tensile Strength (kN/m) | Air Permeance (μm/(Pa·s)) | |
| 1 | 1.50 | 15.00 | 0.10 | 3.50 | 0.78 | 2.91 |
| 2 | 2.50 | 15.00 | 0.10 | 3.61 | 0.81 | 2.39 |
| 3 | 1.50 | 25.00 | 0.10 | 3.51 | 0.77 | 2.30 |
| 4 | 2.50 | 25.00 | 0.10 | 3.70 | 0.78 | 1.98 |
| 5 | 1.50 | 20.00 | 0.05 | 3.51 | 0.76 | 2.99 |
| 6 | 2.50 | 20.00 | 0.05 | 3.67 | 0.85 | 2.38 |
| 7 | 1.50 | 20.00 | 0.15 | 3.49 | 0.79 | 2.68 |
| 8 | 2.50 | 20.00 | 0.15 | 3.59 | 0.75 | 2.38 |
| 9 | 2.00 | 15.00 | 0.05 | 3.47 | 0.85 | 2.36 |
| 10 | 2.00 | 25.00 | 0.05 | 3.52 | 0.81 | 1.71 |
| 11 | 2.00 | 15.00 | 0.15 | 3.36 | 0.79 | 2.23 |
| 12 | 2.00 | 25.00 | 0.15 | 3.49 | 0.79 | 1.60 |
| 13 | 2.00 | 20.00 | 0.10 | 3.67 | 0.80 | 2.00 |
| 14 | 2.00 | 20.00 | 0.10 | 3.65 | 0.81 | 2.02 |
| 15 | 2.00 | 20.00 | 0.10 | 3.66 | 0.81 | 2.02 |
| 16 | 2.00 | 20.00 | 0.10 | 3.64 | 0.82 | 2.04 |
| 17 | 2.00 | 20.00 | 0.10 | 3.66 | 0.80 | 2.05 |
| Source | Sum of Square | df | Mean Square | F Value | p Value | |
|---|---|---|---|---|---|---|
| Dry tensile strength | Model | 0.15 | 9 | 0.02 | 66.10 | <0.0001 |
| Residual | 1.72 × 10−3 | 7 | 2.4 × 10−4 | |||
| Lack of Fit | 1.20 × 10−3 | 3 | 4.00 × 10−4 | 3.08 | 0.1530 | |
| Pure Error | 5.20 × 10−4 | 4 | 1.30 × 10−4 | |||
| Cor Total | 0.15 | 16 | ||||
| Wet tensile strength | Model | 0.01 | 9 | 1.28 × 10−3 | 29.43 | <0.0001 |
| Residual | 3.05 × 10−4 | 7 | 4.36 × 10−5 | |||
| Lack of Fit | 2.50 × 10−5 | 3 | 8.33 × 10−6 | 0.12 | 0.9442 | |
| Pure Error | 2.80 × 10−4 | 4 | 7.00 × 10−5 | |||
| Cor Total | 0.01 | 16 | ||||
| Air permeance | Model | 2.25 | 9 | 0.25 | 145.60 | <0.0001 |
| Residual | 0.012 | 7 | 1.71 × 10−3 | |||
| Lack of Fit | 9.67 × 10−3 | 3 | 3.23 × 10−3 | 5.56 | 0.0654 | |
| Pure Error | 2.32 × 10−3 | 4 | 5.80 × 10−4 | |||
| Cor Total | 2.26 | 16 | ||||
| Item | DTS (kN/m) | WTS (kN/m) | AP (μm/(Pa·s)) | |
|---|---|---|---|---|
| WFM | 3.27 ± 0.13 | 0.70 ± 0.04 | 2.40 ± 0.32 | |
| C-CS-WFM | predicted value | 3.66 | 0.81 | 2.04 |
| measured value | 3.64 ± 0.01 | 0.80 ± 0.01 | 1.99 ± 0.02 | |
| Model | R2 | Modify R2 |
|---|---|---|
| The first-order kinetic model | 0.9119 | 0.9056 |
| Higuchi kinetic model | 0.9734 | 0.9735 |
| Ritger–Peppas kinetic model | 0.9831 | 0.9819 |
Disclaimer/Publisher’s Note: The statements, opinions and data contained in all publications are solely those of the individual author(s) and contributor(s) and not of MDPI and/or the editor(s). MDPI and/or the editor(s) disclaim responsibility for any injury to people or property resulting from any ideas, methods, instructions or products referred to in the content. |
© 2024 by the authors. Licensee MDPI, Basel, Switzerland. This article is an open access article distributed under the terms and conditions of the Creative Commons Attribution (CC BY) license (https://creativecommons.org/licenses/by/4.0/).
Share and Cite
Liu, S.; Jin, Z.; Zhou, P.; Shang, H.; Yang, H.; Li, L.; Li, R.; Zhang, Y.; Chen, H. Preparation of Wheat-Straw-Fiber-Based Degradable Mulch Film for Sustained Release of Carbendazim and Its Application for Soybean Root Rot Control. Agronomy 2025, 15, 71. https://doi.org/10.3390/agronomy15010071
Liu S, Jin Z, Zhou P, Shang H, Yang H, Li L, Li R, Zhang Y, Chen H. Preparation of Wheat-Straw-Fiber-Based Degradable Mulch Film for Sustained Release of Carbendazim and Its Application for Soybean Root Rot Control. Agronomy. 2025; 15(1):71. https://doi.org/10.3390/agronomy15010071
Chicago/Turabian StyleLiu, Shuang, Zhe Jin, Pengfei Zhou, Huimin Shang, Haiyan Yang, Longhai Li, Rui Li, Ying Zhang, and Haitao Chen. 2025. "Preparation of Wheat-Straw-Fiber-Based Degradable Mulch Film for Sustained Release of Carbendazim and Its Application for Soybean Root Rot Control" Agronomy 15, no. 1: 71. https://doi.org/10.3390/agronomy15010071
APA StyleLiu, S., Jin, Z., Zhou, P., Shang, H., Yang, H., Li, L., Li, R., Zhang, Y., & Chen, H. (2025). Preparation of Wheat-Straw-Fiber-Based Degradable Mulch Film for Sustained Release of Carbendazim and Its Application for Soybean Root Rot Control. Agronomy, 15(1), 71. https://doi.org/10.3390/agronomy15010071

